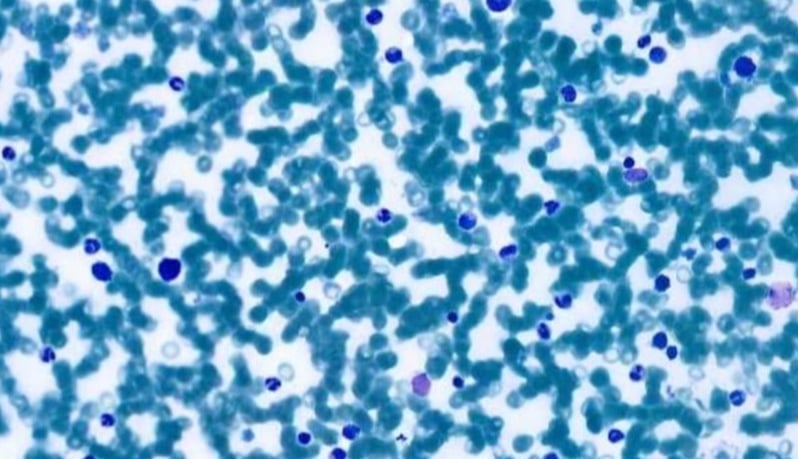
leonie-satf-project-bone-marrow-detection-2

Related materials:
Harmony on the horizon – could AI standardize breast cancer grading?
Related materials:
Related materials:
Related materials:
Explore the case studies from Aiforia's users

Case study: enhancing mesothelioma research with AI
A research team from the University of Turin used Aiforia® Create to build an AI model for mesothelioma subtyping with reticulin stain. Read more or watch the video interview.
Case study: automated detection and classification of bone marrow cells
Developing a deep learning algorithm for the automated detection and classification of bone marrow aspirate smears in cytological preparations.
/Other%20medical%20areas%20JPEG/kidney_cortex_medulla_after.jpeg?width=800&height=459&name=kidney_cortex_medulla_after.jpeg)
Galileo case study: exploring AI’s potential in kidney transplantation
An Italian research team built an AI model for kidney pathology to assist on-call pathologists and renal pathologists in their routine work.

Orion pharma case study: accelerating preclinical neurotoxicity analysis with AI
Scientists at the pharmaceutical company Orion Pharma developed artificial intelligence models to automate preclinical neurotoxicity assessment.

MIT case study: advancing lung cancer research with AI
Reseachers at the Tyler Jacks Lab, MIT, created artificial intelligence models to automate tumor grading as part of their lung cancer research studies.

Massachusetts General Hospital case study: AI-assisted image analysis of neurodegenerative disease markers
Researchers from Massachusetts General Hospital used Aiforia’s AI for the analysis of histopathological markers in neurodegenerative diseases.

Faron Pharmaceuticals case study: using AI to perform spatial analysis in cancer drug development
Elisa Vuorinen at Faron Pharmaceuticals built an AI model to quantify and localize Clever-1 in the tumor microenvironment using Aiforia® Create.

Sanofi case study: Parkinson's disease research with AI
The preclinical research team studying Parkinson's disease at Sanofi created their own AI model with Aiforia® Create to automate Th+ neuron quantification.

CRL case study: AI-assisted screening of bone marrow cellularity changes
CRL Veterinary Pathologist Mark Smith describes using AI models to screen for bone marrow cellularity changes.

Experimentica case study: accelerating preclinical analysis of ocular diseases
Scientists at the CRO Experimentica describe using AI to analyze Spectral Domain Optical Coherence Tomography scans to identify neovascular lesions.
Request a demo
Discover the power of AI for image analysis
Find out how to enhance your image analysis work in diagnostic pathology, preclinical studies, or medical research. The demo will be tailored based on your interests.
The demo will help you understand:
- How AI-assisted image analysis can increase efficiency, precision, and consistency in the pathology workflow.
- The limitless possibilities Aiforia® Platform offers – both for research and clinical diagnostics – and the suitable use cases for your needs.
We can either demonstrate Aiforia’s image analysis solutions on your own images or any of our application examples (i.e., neuron quantification, automated tumor grading, NASH analysis, etc.).
Fill in the form, and one of our experts will contact you shortly to schedule the time.